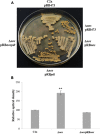

Evidence for Nitric Oxide Synthase Activity in Staphylococcus xylosus Mediating Nitrosoheme Formation
- PMID: 28428778
- PMCID: PMC5382197
- DOI: 10.3389/fmicb.2017.00598
Evidence for Nitric Oxide Synthase Activity in Staphylococcus xylosus Mediating Nitrosoheme Formation
Abstract
Staphylococcus xylosus is used as a starter culture in fermented meat products and contributes to color formation by the reduction of nitrate to nitrite. Nitrite is a food additive that is chemically turned to nitric oxide (NO) in meat but its safety has been questioned. The objective of this study was to determine the ability of NO synthase (NOS) of S. xylosus C2a to produce NO. For this purpose, a nos deletion mutant (Δnos) in S. xylosus was constructed and NO production was evaluated in a test based on its ability to form nitrosomyoglobin and nitrosoheme. Production of NO was abrogated in the Δnos mutant under aerobic conditions and reduced about 35-40% comparing to the wild type C2a under limited oxygenation. This mutant was sensitive to oxidative stress. The expression of genes encoding catalase was modulated in the mutant with an up-regulation of katA and a down-regulation of katB and katC. The Δnos mutant displayed high colony pigmentation after prolonged growth on agar medium. Finally, the Δnos mutant showed no growth in minimal medium. Growth was not restored in the minimal medium by complementation with nos, but was restored by either addition of phenylalanine or complementation with pdt, a gene that encodes a prephenate dehydratase involved in phenylalanine biosynthesis and co-transcribed with nos. Our findings clearly demonstrate NOS-mediated NO production in S. xylosus, a meat-associated coagulase-negative Staphylococcus.
Keywords: Staphylococcus xylosus; coagulase-negative Staphylococcus; nitric oxide; nitric oxide synthase; nitrosoheme; oxidative stress.
Figures

References
-
- Barrière C., Brückner R., Centeno D., Talon R. (2002). Characterisation of the katA gene encoding a catalase and evidence for at least a second catalase activity in Staphylococcus xylosus, bacteria used in food fermentation. FEMS Microbiol. Lett. 216 277–283. 10.1016/S0378-1097(02)01030-3 - DOI - PubMed
LinkOut - more resources
Full Text Sources
Other Literature Sources